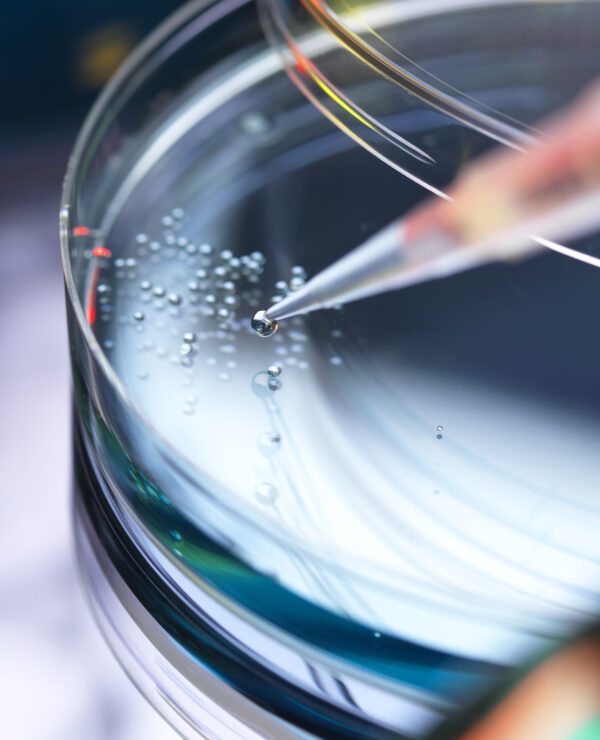

Professionnel(s) mentionné(s)
Associé, Litiges, Toronto
Associée, Litiges, Toronto
Associé directeur du bureau d'Ottawa, Ottawa
Ancien coprésident national, Associé, Droit des sociétés, Montréal
Associée, Litiges, Toronto
Associé, Propriété Intellectuelle, Toronto
Osler félicite les six membres du cabinet pour leur classement dans la catégorie « Recommandé » du Who's Who Legal (WWL) Life Sciences – Canada. Les avocats et avocates qui obtiennent ce classement sont « des personnes considérées comme des chefs de file dans leur domaine. Moins de 50 % des personnes susceptibles de figurer au classement le sont réellement. » Avant de publier ses recommandations, le WWL mène un processus de recherche rigoureux qui passe par un examen du travail de chaque candidat et candidate et par des questions posées à ses clients et ses pairs.
Nos avocats et avocates reconnus sont les suivants :
- Craig Lockwood, associé, Litige
- J. Bradley White, associé, chef, Litige en matière de propriété intellectuelle
- Laura Fric, associée, Litige
- Nathaniel Lipkus, associé, Propriété intellectuelle
- Shahir Guindi, ancien coprésident national, associé, Droit des sociétés
- Sonia Bjorkquist, associée, chef nationale, Litige,
Pour en savoir plus sur WWL Life Sciences — Canada.
Professionnel(s) mentionné(s)
Associé, Litiges, Toronto
Associée, Litiges, Toronto
Associé directeur du bureau d'Ottawa, Ottawa
Ancien coprésident national, Associé, Droit des sociétés, Montréal
Associée, Litiges, Toronto
Associé, Propriété Intellectuelle, Toronto